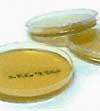

|
 |
||||
|
|
|
|
|
|
|
TYPES OF MOLD
Allergenic molds are normally not dangerous in low amounts, but they can cause allergenic or asthmatic symptoms such as wheezing or runny nose. These molds can be abated safely with the assistance of gloves and a disposable particulate-removing respirator.
 Mycotoxic molds can cause serious health effects in humans and animals. Health effects range from short-term irritation to possibly cancer. If any toxic molds are identified, it is suggested that you seek advice from an Industrial Hygienist or other mold professional for guidance. The average homeowner should NOT attempt the abatement of these types of mold.
Mycotoxic molds can cause serious health effects in humans and animals. Health effects range from short-term irritation to possibly cancer. If any toxic molds are identified, it is suggested that you seek advice from an Industrial Hygienist or other mold professional for guidance. The average homeowner should NOT attempt the abatement of these types of mold.
Pathogenic molds can cause serious health effects in persons with suppressed immune systems, those taking chemotherapy, HIV/AIDS, or autoimmunity disorders. If any pathogenic molds are identified, it is suggested you seek the advice of an Industrial Hygienist or other mold professional for guidance. The average homeowner should NOT attempt the abatement of these types of mold.
Hyphae & Hyphal elements refer to single, unidentifiable fragments of mold. Although they may not be traceable to a specific mold species, the fragments themselves may be responsible for allergic reactions in some people and may indicate previous or current growth event. Smut spores are agricultural spores from outside sources. Ascospores and Basidiospores are clusters of mushroom spores that may not be easily identified as per specific species, but may still represent a mold problem in the home.
Hyphae & Hyphal elements refer to single, unidentifiable fragments of mold. Although they may not be traceable to a specific mold species, the fragments themselves may be responsible for allergic reactions in some people and may indicate previous or current growth event. Smut spores are agricultural spores from outside sources. Ascospores and Basidiospores are clusters of mushroom spores that may not be easily identified as per specific species, but may still represent a mold problem in the home.
TYPES OF ALLERGENS
Dust mites are ubiquitous in nature and are found in every household. Mites prefer warm, moist surroundings such as the inside of a mattress when someone is on it. Humans, on average, shed about 1/5 ounce of dander (dead skin) each week, and a favorite food for the dust mites is dander (both human and animal skin flakes).
Cats and dogs are the most common animal cohabitants present in almost more than 1/3 of homes in the United States. Those who touch cats and dogs or visit households with cats and dogs easily carry these allergens from home to home, office, school, etc. These pet allergens are carried in minute particles and can remain airborne for long periods of time.
Coakroaches are an important source of indoor allergens worldwide. The sources of cockroach allergens include the gastrointestinal tract, saliva, feces and body parts of the cockroach. As cockroaches die in a dwelling, their decomposing body parts become part of the environmental dust. These sources contain cockroach allergens.
Rodents (mouse and rat) can be found to occur in both home and work environments. The sources of rodent allergen include the rodent urine and skin flakes. The rodent's urine has a high concentration of protein, which is the primary allergen to humans. The urine is often sprayed rather than deposited, thereby increasing human exposure. After the urine dries, the urinary proteins become airborne and are inhaled by humans, leading to allergic symptoms.
> Why does mold or allergens grow in my house?
> What can it do to me and my family?
> How can I check if I have it in my house?